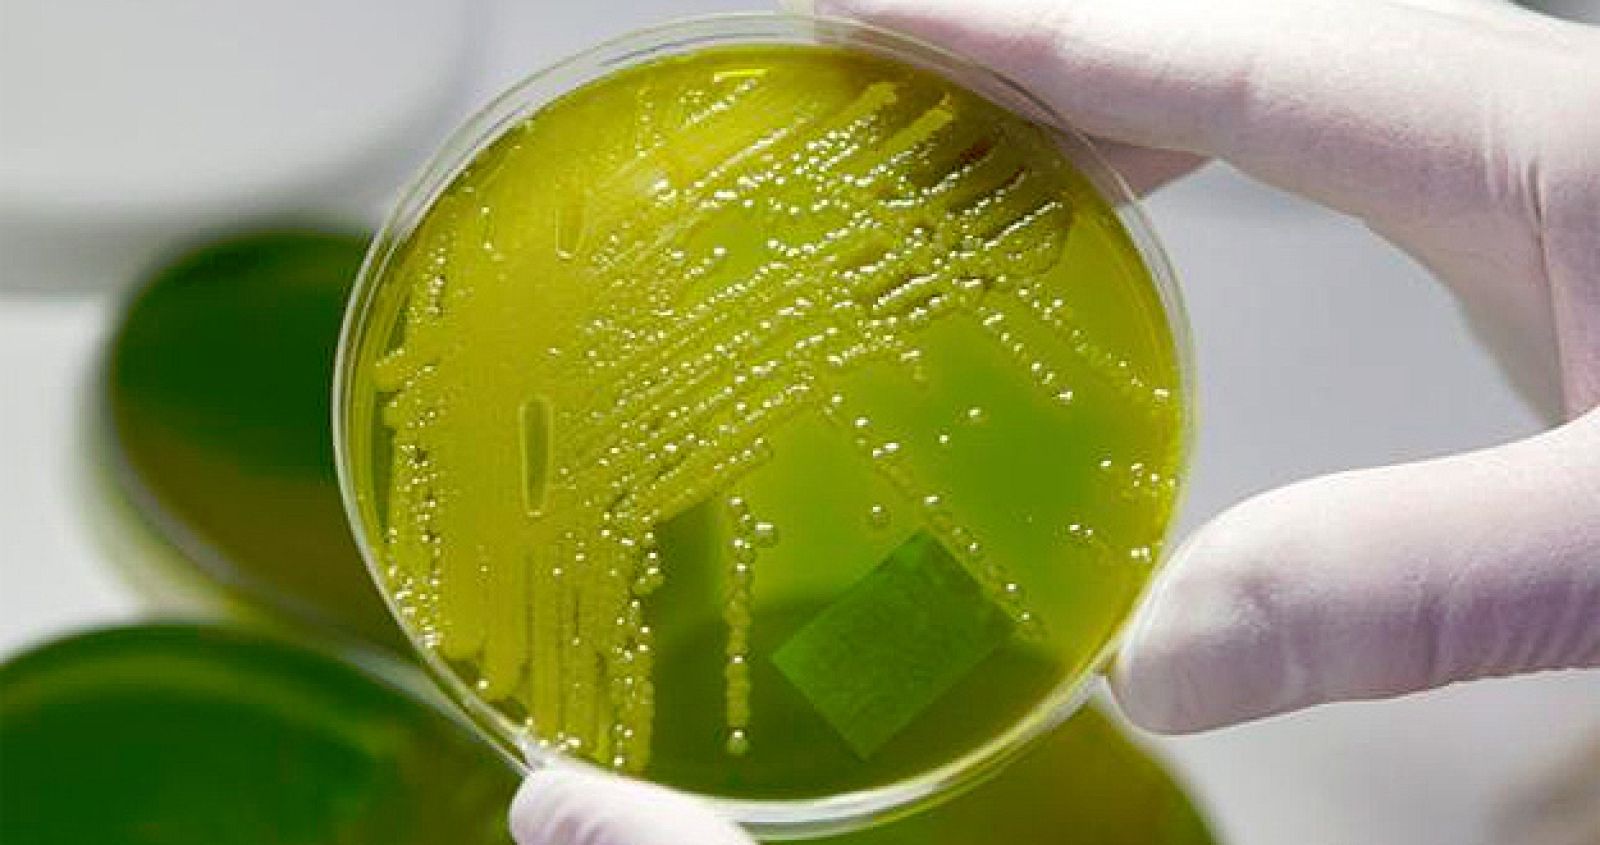
Bacteria E. coli

Alertan del riesgo real de quedarse sin antibióticos para bacterias multirresistentes
- Cada año mueren 25.000 personas en Europa por bacterias multirresistentes
- Este viernes es el Día Europeo para el Uso Prudente de Antibióticos

La Sociedad Española de Enfermedades Infecciosas y Microbiología Clínica (SEIMC) ha alertado del riesgo real de quedarse sin antibióticos eficaces para tratar determinadas infecciones bacterianas.
Así lo ha manifestado el doctor Jesús Otero, investigador del Laboratorio de Antibióticos del Centro Nacional de Microbiología y miembro de la SEIMC, quien ha recordado que "el número de nuevos antibióticos en investigación es escaso", según informa esta sociedad científica en un comunicado.
Con motivo de la celebración de este viernes del Día Europeo para el Uso Prudente de Antibióticos, la SEIMC ha incidido en la importancia de utilizar este tipo de medicamentos de forma adecuada, para de esta manera evitar que las bacterias se vuelvan resistentes y los antibióticos dejen de tener eficacia.
Este día, promocionado y coordinado por el Centro Europeo para la Prevención y el Control de las Enfermedades (ECDC) desde 2008, pretende dar a conocer la amenaza que supone para los ciudadanos europeos hacer un uso abusivo o incorrecto de los antibióticos.
"Nos estamos quedando sin antibióticos eficaces debido a la rápida progresión de las resistencias y esta progresión se produce en gran parte por su uso incorrecto", ha señalado.
La resistencia a los antibióticos es un problema de salud pública que pone en riesgo a aquellos pacientes que necesitan o van a necesitar estos fármacos en situaciones críticas para su salud, ha apuntado la SEIMC.
Uno de los principales problemas en relación con las bacterias resistentes es la pérdida de alternativas de tratamiento antibiótico frente a las infecciones producidas por bacterias multirresistentes, aquellas que son resistentes a tres o más familias de antibióticos.
Se dice que una bacteria ha desarrollado resistencia cuando un antibiótico específico pierde su capacidad para eliminarla o para detener su crecimiento.
25.000 muertes al año en Europa por bacterias multirresistentes
La SEIMC ha incidido en que el tratamiento con antibióticos inadecuados y el retraso en la administración de un tratamiento correcto está relacionado en aquellos pacientes con infecciones graves con una peor evolución clínica y, en ocasiones, con la muerte.
El ECDC estima que más de 25.000 pacientes mueren al año en Europa por bacterias multirresistentes y que los gastos anuales por prolongación de la estancia hospitalaria y pérdidas de productividad debido a este motivo son superiores a los 1.500 millones de euros.
Los datos más recientes confirman que el número de pacientes infectados por bacterias resistentes está aumentando de forma alarmante en la Unión Europea y en concreto en España.



